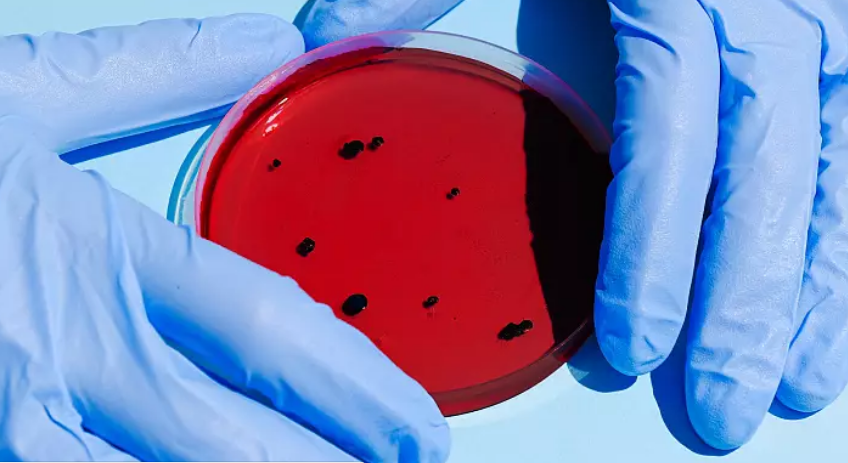

Исследователи обнаружили в России новый вариант коронавируса, который представляет собой гибрид штаммов «омикрон» и «дельта». Опасность «российского дельтакрона» еще предстоит изучить, рассказал РБК американский ученый-генетик Дмитрий Прусс.
Штамм коронавируса «дельта» был впервые описан в Индии в конце 2020 года и некоторое время был доминирующим в большинстве стран мира.
Однако в 2021 году его начал быстро вытеснять более заразный штамм «омикрон», впервые выявленный в Южной Африке. В итоге именно этот штамм, более заразный и вызывающий в большинстве случаев менее тяжелое течение болезни, стал доминирующим.
В июне Роспотребнадзор сообщал, что на «омикрон» приходится почти 98,3% всех выявляемых в стране случаев COVID-19.
Как рассказал РБК Прусс, вирусы, сочетающие в себе фрагменты геномов «омикрона» и «дельты» — это большая редкость, поскольку штамм «дельта» практически исчез. «Однако именно такие необычные гибридные вирусы обнаружили в последних загрузках геномных данных из Петербурга.
Первые из них появились в базах в начале июля, и были встречены с легким недоверием.
Но к концу июля исследователи из Института гриппа имени Смородинцева нашли еще больше таких геномов. Перепроверили все, что могли, и пришли к уверенному выводу: это не ошибка, а действительно гибридный вирус», — рассказал ученый.
Ни в одной другой стране мира этот вид коронавируса пока не был выявлен, отмечает Прусс, поэтому, вероятнее всего, его родина — Россия.
Тем не менее распространенность штамма пока невелика, по крайней мере в Петербурге, где проводил исследования Институт гриппа.«Опасен ли недавно открытый «русский дельтакрон», еще предстоит определить. Неизвестно, может ли он вытеснить другие штаммы. Неизвестно также, может ли он вызвать тяжелый ковид. У исходной «дельты» есть способность поражать легкие, которая ослабла у «омикрона», но как это передастся гибриду?
Лучшее, что я бы посоветовал российским медицинским организациям, это усилить отслеживание новых штаммов. Тут и более активное прочтение геномов нужно, и более прозрачная отчетность с загрузкой в мировые базы, и даже случайное тестирование на ковид. Без этого недостаточно данных, чтобы сказать, не пора ли добавить мер эпидемиологического контроля», — констатирует Прусс.
Между тем, в России по состоянию на 10 августа было выявлено шесть случаев нового варианта коронавируса, который представляет собой гибрид штаммов «омикрон» и «дельта». Пять образцов для исследований взяты в Санкт-Петербурге, один – в Москве. Об этом сообщает Роспотребнадзор.
Сообщается, что вариант относится к недоминирующим линиям COVID-19 и в настоящий момент не оказывает значимого влияния на эпидобстановку ни в Санкт-Петербурге, ни в Москве. Эпидситуация в этих городах аналогична ситуации в целом по стране и характеризуется активным распространением субвариантов COVID-19 BA.4/BA.5 с преобладанием BA.5 в штаммовом составе.
Пациенты, у которых был выявлен гибридный вариант COVID-19, перенесли болезнь в лёгкой форме. Госпитализация ни одному из них не потребовалась.
В настоящий момент нет оснований считать, что гибридный вариант приводит к более тяжёлому течению болезни или обладает большей трансмиссивностью, отметили в ведомстве.
Читайте нас в Telegram, Facebook, Instagram, Яндекс.Дзен, OK и ВК.